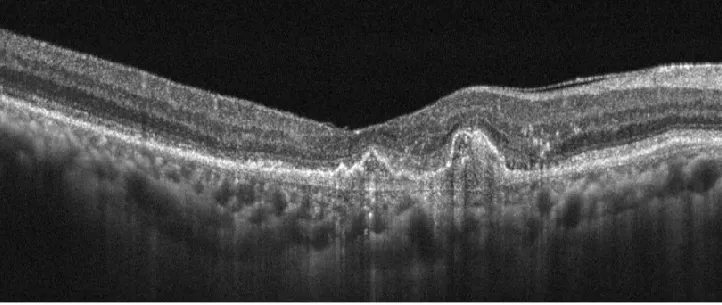

抗VEGF硝子体内注射
HOME > 抗VEGF硝子体内注射
Anti-VEGF intravitreal injection
抗VEGF硝子体内注射
抗VEGF硝子体内注射
加齢黄斑変性症や、糖尿病網膜症などで視力が下がったときに、目の中に注射して、薬液を注入します。
加齢黄斑変性症の注射前後

抗VEGF硝子体内注射
加齢黄斑変性症や、糖尿病網膜症などで視力が下がったときに、目の中に注射して、薬液を注入します。
加齢黄斑変性症の注射前後